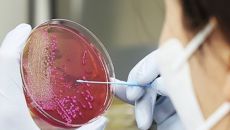

2026
일
월
화
수
목
금
토
-

정원오 보는 상반된 시각, "보수도 좋아해" vs "중앙정치 경험 없어"[시사쇼]
■방송 : 아시아경제 '소종섭의 시사쇼'(월~금·오후 4~5시) ■ 진행 : 소종섭 정치스페셜리스트 ■ 연출 : 이경도 PD- 2026-03-06 15:44
- 아시아경제
-

청년 공공임대주택 찾은 김민석 국무총리
[서울=뉴스핌] 정일구 기자 = 김민석 국무총리가 6일 오후 서울 관악구 관악봉천 청년 공공임대주택을 방문해 주요 시설을 둘러- 2026-03-06 15:43
- 뉴스핌
-

정읍 내장산 방문객 3459만명, 소비액 2.7% 증가…지역상권에 '훈풍'
[송부성 기자(=정읍)(bss20c@naver.com)] 전북 정읍시 지난해 방문객이 증가하면서 지역 소비액이 전년 대비 2%- 2026-03-06 15:43
- 프레시안
-

주러 中 대사 “이란 사태에 대해 중-러 지속적으로 소통”
[서울=뉴시스] 구자룡 기자 = 장한후이(張漢暉) 주러시아 중국 대사는 5일 미국의 이란 공격을 주권 국가에 대한 침략 행위이- 2026-03-06 15:43
- 뉴시스
-

행복주택 방문해 시설 점검하는 김민석 총리
[서울=뉴스핌] 정일구 기자 = 김민석 국무총리가 6일 오후 서울 관악구 관악봉천 청년 공공임대주택을 방문해 주요 시설을 둘러- 2026-03-06 15:43
- 뉴스핌
-

셀트리온 '스테키마', 글로벌 임상 3상 장기 데이터 국제학술지 게재
셀트리온은 자가면역질환 치료제 '스테키마(성분명 우스테키누맙)'의 글로벌 임상 3상 52주 결과가 피부과 국제 학술지 '국제피- 2026-03-06 15:43
- 전자신문
-

두바이 발묶인 국민들, UAE 특별기 타고 귀국
중동 지역 긴장 고조로 현지에 체류 중인 우리 국민들의 귀국과 에너지 수급 불안에 대한 우려가 커지는 가운데 정부가 아랍에미리- 2026-03-06 15:43
- 노컷뉴스
-
"학생 안전환경 조성" 강원도 '식중독 예방' 관리 강화
강원특별자치도는 신학기를 맞아 도내 학교, 학교 식재료 공급업체를 대상으로 식중독 예방 합동점검을 실시하고 학교 주변 식품 조- 2026-03-06 15:43
- 노컷뉴스
-

김민석 총리, 청년 행복주택 시설 점검
[서울=뉴스핌] 정일구 기자 = 김민석 국무총리가 6일 오후 서울 관악구 관악봉천 청년 공공임대주택을 방문해 주요 시설을 둘러- 2026-03-06 15:43
- 뉴스핌
-

청년 공공임대주택 시설 둘러보는 김민석 총리
[서울=뉴스핌] 정일구 기자 = 김민석 국무총리가 6일 오후 서울 관악구 관악봉천 청년 공공임대주택을 방문해 주요 시설을 둘러- 2026-03-06 15:43
- 뉴스핌
-

'뒷돈받고 기밀유출' 삼성전자 前직원, 법정서 "비밀누설 아냐"
(서울=연합뉴스) 이영섭 기자 = 사내 기밀정보를 유출하고 10억원 넘는 뒷돈을 받은 혐의로 기소된 삼성전자 전 직원이 법정에- 2026-03-06 15:43
- 연합뉴스
-

김민석 총리, 청년 공공임대주택 둘러보는 김민석 총리
[서울=뉴스핌] 정일구 기자 = 김민석 국무총리가 6일 오후 서울 관악구 관악봉천 청년 공공임대주택을 방문해 주요 시설을 둘러- 2026-03-06 15:43
- 뉴스핌
-

남원 봄꽃 릴레이 여행…산수유·벚꽃·철쭉 명소 주목
[서울경제TV 전북=최영 기자] 산수유와 벚꽃, 철쭉으로 이어지는 '봄꽃 릴레이'가 펼쳐지며 전북 남원시가 봄철 대표 여행지로- 2026-03-06 15:43
- 서울경제TV
-

관악봉천 청년 공공임대주택 찾은 김민석 총리
[서울=뉴스핌] 정일구 기자 = 김민석 국무총리가 6일 오후 서울 관악구 관악봉천 청년 공공임대주택을 방문해 주요 시설을 둘러- 2026-03-06 15:43
- 뉴스핌
-

경기도·국토부·안산시 등 8개 기관 '안산선 지하화 사업' 성공 위해 '맞손'
[수원=뉴스핌] 박승봉 기자 = 경기도가 국토교통부, 안산시 및 5개 전문기관과 함께 안산선 지하화 통합개발사업의 성공적인 추- 2026-03-06 15:43
- 뉴스핌

